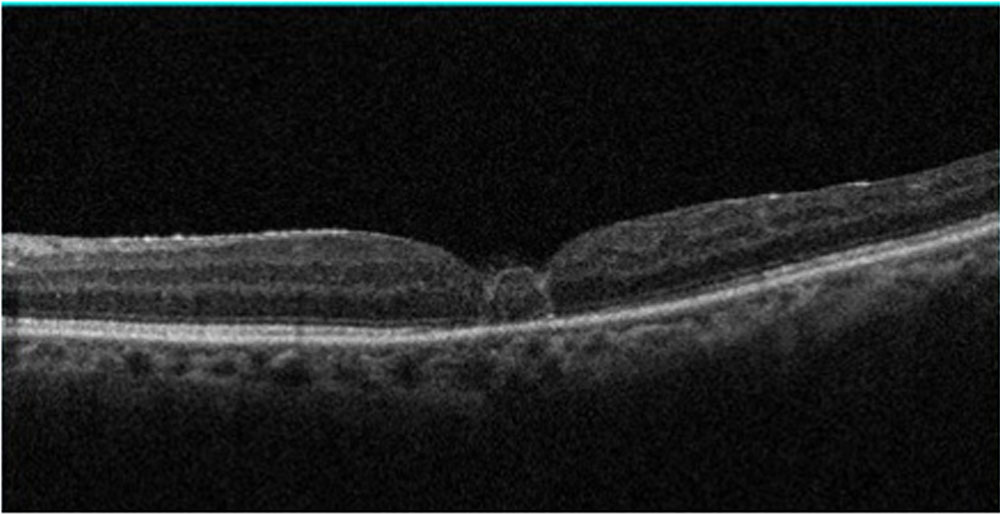
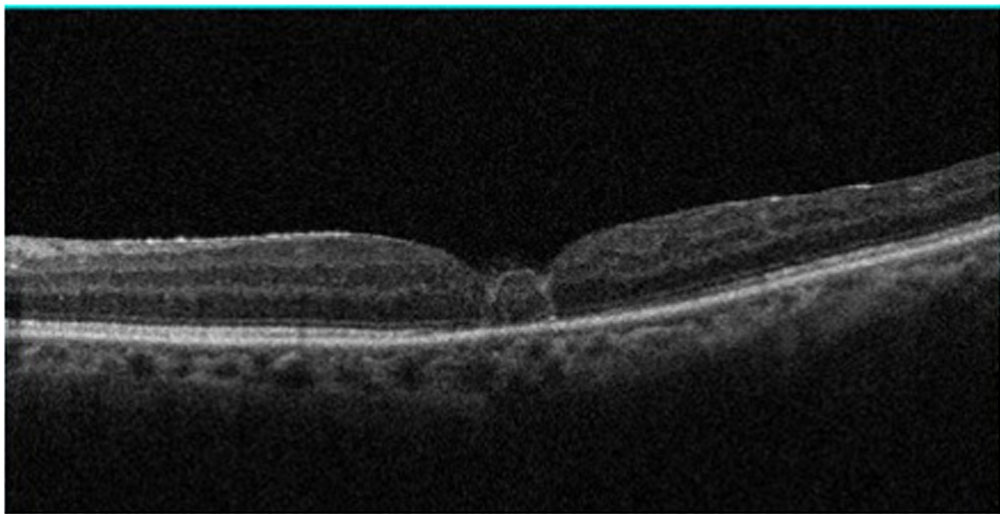

Vitreo Retinal Diseases – II
Crafting macula with grafting
Chief Author : Dr. Rupak Kanti Biswas
Co Authors : Dr.Sourav Sinha,Dr.Surendra Prakash,Dr.Swakshyar Pal
Non closure following full thickness macular hole surgery is not a very uncommon outcome. People have tried a lot to tackle this situation, like autologus serum [1], anterior capsular bit [2], free ILM flap [3] etc. but, none of them can replace the gap with retinal tissue. They fill it with scar tissue, which can not function like a retinal tissue.
Before first surgery

After first surgery
Author has got the innovative idea of filling it with retinal tissue itself. So, he has designed a trephine to cut almost same size of retinal tissue from superior fundus just outside the arcade. In well accepted grafts, visual improvement is probably due to aberrant regeneration at graft-host junction.
Figure 1: Pre and Post Operative OCT of first surgery
 Figure 2: Graft filled with scar tissue only in a different patient
Figure 2: Graft filled with scar tissue only in a different patient
Figure 3: Graft tissue filling the gap shown in Fig 1. It shows normal retina like layers.
Figure 3: Graft tissue filling the gap shown in Fig 1. It shows normal retina like layers.
Figure 4: Different section of same patient as in Fig 3
Figure 4: Different section of same patient as in Fig 3
Till now 7 eyes underwent grafting in failed macular hole cases. Multifocal ERG (MFERG) shows moderate to good macular spike in well grafted cases.

|
In his paper Grewal et al [4], described a similar situation of refractory macular hole in a myopic eye. They have used a free retinal flap to cover the hole. Our method is unique, considering the fact that almost same size of retinal tissue is trephined to fill the gap and to produce end to end contact between graft and host tissues, unlike Grewal’s method where a bigger size of flap is harvested.
We hypothesize that there is some aberrant neural connection might have developed between graft-host junction , which is responsible for good visual and MFERG response.
References:
1. Lai CC, Chen YP,Wang NK, et al. Vitrectomy with internal limiting membrane repositioning and autologous blood for macular hole retinal detachment in highlymyopic eyes. Ophthalmology. 2015;122(9):1889-1898.
2. Chen SN, Yang CM. Lens Capsular Flap Transplantation in the Management of Refractory Macular Hole from Multiple Etiologies [published online July 21, 2015]. Retina. doi:10.1097/IAE.0000000000000674.
3. Morizane Y, Shiraga F, Kimura S, et al. Autologous transplantation of the internal limiting membrane for refractory macular holes. Am J Ophthalmol. 2014;157(4):861-869.e1.
4. Dilraj S. Grewal, Tamer H. Mahmoud: Autologous Neurosensory Retinal Free Flap for Closure of Refractory Myopic Macular Holes: JAMA Ophthalmology Published online December 30, 2015: E1-E2


Leave a Comment